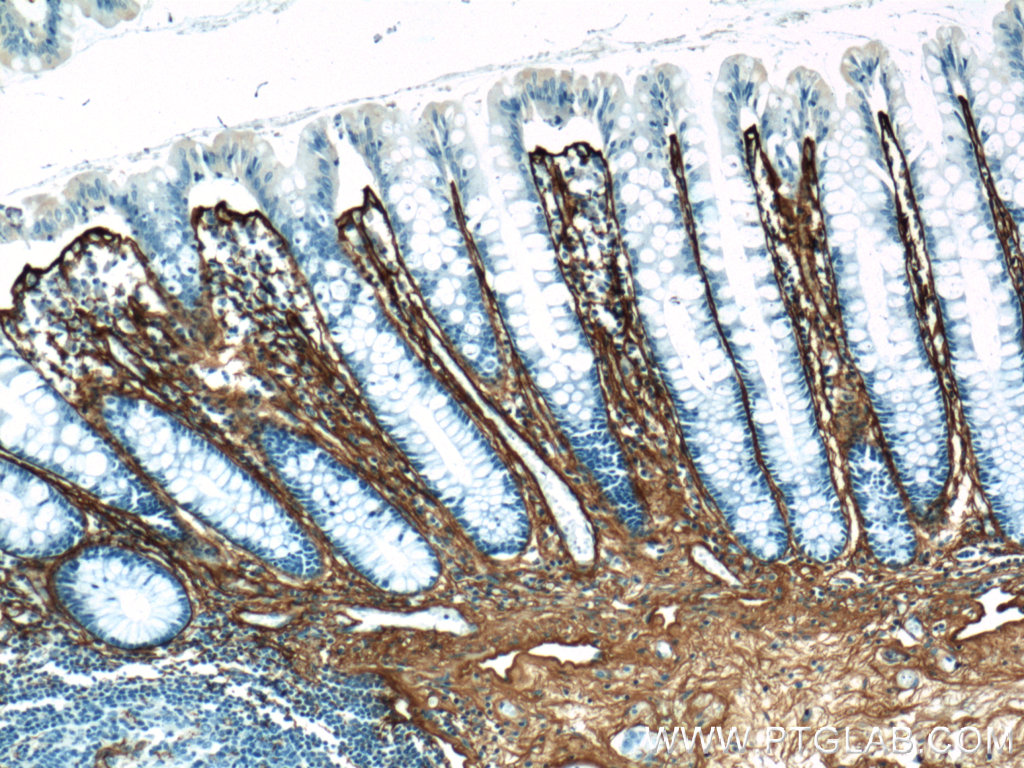
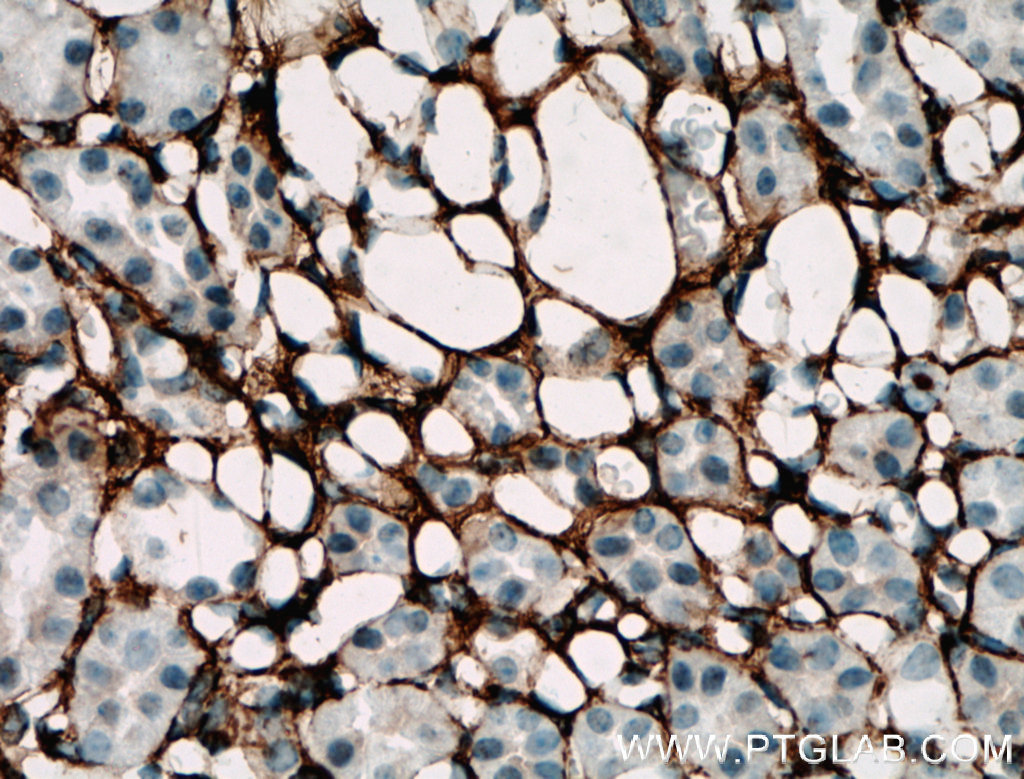

验证数据展示
经过测试的应用
| Positive WB detected in | mouse skin tissue, rat skin tissue |
| Positive IP detected in | mouse skin tissue |
| Positive IHC detected in | human hepatocirrhosis tissue, human pancreas cancer tissue, mouse liver tissue, mouse kidney tissue, human colon tissue, human skin cancer tissue, mouse heart tissue, mouse colon tissue, human skin tissue, human malignant melanoma tissue Note: suggested antigen retrieval with TE buffer pH 9.0; (*) Alternatively, antigen retrieval may be performed with citrate buffer pH 6.0 |
| Positive IF-P detected in | human colon tissue |
| Positive IF-Fro detected in | mouse colon tissue |
推荐稀释比
| 应用 | 推荐稀释比 |
|---|---|
| Western Blot (WB) | WB : 1:300-1:1000 |
| Immunoprecipitation (IP) | IP : 0.5-4.0 ug for 1.0-3.0 mg of total protein lysate |
| Immunohistochemistry (IHC) | IHC : 1:500-1:2000 |
| Immunofluorescence (IF)-P | IF-P : 1:50-1:500 |
| Immunofluorescence (IF)-FRO | IF-FRO : 1:50-1:500 |
| It is recommended that this reagent should be titrated in each testing system to obtain optimal results. | |
| Sample-dependent, Check data in validation data gallery. | |
产品信息
22734-1-AP targets Collagen Type III (N-terminal) in WB, IHC, IF-P, IF-Fro, IP, CoIP, ELISA applications and shows reactivity with human, mouse, rat samples.
| 经测试应用 | WB, IHC, IF-P, IF-Fro, IP, ELISA Application Description |
| 文献引用应用 | WB, IHC, IF, CoIP |
| 经测试反应性 | human, mouse, rat |
| 文献引用反应性 | human, mouse, rat, pig, rabbit, canine, chicken, bovine, hamster |
| 免疫原 |
CatNo: Ag18658 Product name: Recombinant human COL3A1 protein Source: e coli.-derived, PGEX-4T Tag: GST Domain: 24-152 aa of BC028178 Sequence: QQEAVEGGCSHLGQSYADRDVWKPEPCQICVCDSGSVLCDDIICDDQELDCPNPEIPFGECCAVCPQPPTAPTRPPNGQGPQGPKGDPGPPGIPGRNGDPGIPGQPGSPGSPGPPGICESCPTGPQNYS 种属同源性预测 |
| 宿主/亚型 | Rabbit / IgG |
| 抗体类别 | Polyclonal |
| 产品类型 | Antibody |
| 全称 | collagen, type III, alpha 1 |
| 别名 | COL3, COL3A1, Collagen alpha 1(III) chain, Collagen alpha-1(III) chain, Collagen Type III |
| 计算分子量 | 1466 aa, 139 kDa |
| 观测分子量 | 140-180 kDa |
| GenBank蛋白编号 | BC028178 |
| 基因名称 | COL3A1 |
| Gene ID (NCBI) | 1281 |
| RRID | AB_2879158 |
| 偶联类型 | Unconjugated |
| 形式 | Liquid |
| 纯化方式 | Antigen affinity purification |
| UNIPROT ID | P02461 |
| 储存缓冲液 | PBS with 0.02% sodium azide and 50% glycerol, pH 7.3. |
| 储存条件 | Store at -20°C. Stable for one year after shipment. Aliquoting is unnecessary for -20oC storage. |
背景介绍
Type III collagen is a fibrillar forming collagen comprising three α1(III) chains and is expressed in early embryos and throughout embryogenesis (PMID: 9050868). In the adult, type III collagen is a major component of the extracellular matrix in a variety of internal organs and skin. It occurs in most soft connective tissues along with type I collagen (PMID: 2445760). COL3A1 gene encodes type III procollagen. Mutations in this gene are associated with Ehlers-Danlos syndrome types IV, and with aortic and arterial aneurysms (PMID: 10706896; 2243125; 18389341). This antibody raised against 24-152 aa of prepro α1 (III) chain of human type III procollagen detects type III procollagen at 140-180 kDa and also in some lysates reveals a 70-kDa band which has been reported and may represent a cleaved form of type III procollagen (PMID: 17424834; 19648160; 22802960).
实验方案
| Product Specific Protocols | |
|---|---|
| IF protocol for Collagen Type III (N-terminal) antibody 22734-1-AP | Download protocol |
| IHC protocol for Collagen Type III (N-terminal) antibody 22734-1-AP | Download protocol |
| IP protocol for Collagen Type III (N-terminal) antibody 22734-1-AP | Download protocol |
| WB protocol for Collagen Type III (N-terminal) antibody 22734-1-AP | Download protocol |
| Standard Protocols | |
|---|---|
| Click here to view our Standard Protocols |
发表文章
| Species | Application | Title |
|---|---|---|
Nat Aging Single-cell and spatial RNA sequencing identify divergent microenvironments and progression signatures in early- versus late-onset prostate cancer | ||
Adv Sci (Weinh) LIMA1 O-GlcNAcylation Promotes Hepatic Lipid Deposition through Inducing β-catenin-Regulated FASn Expression in Metabolic Dysfunction-Associated Steatotic Liver Disease | ||
Acta Pharm Sin B SMYD3-PARP16 axis accelerates unfolded protein response and mediates neointima formation. | ||